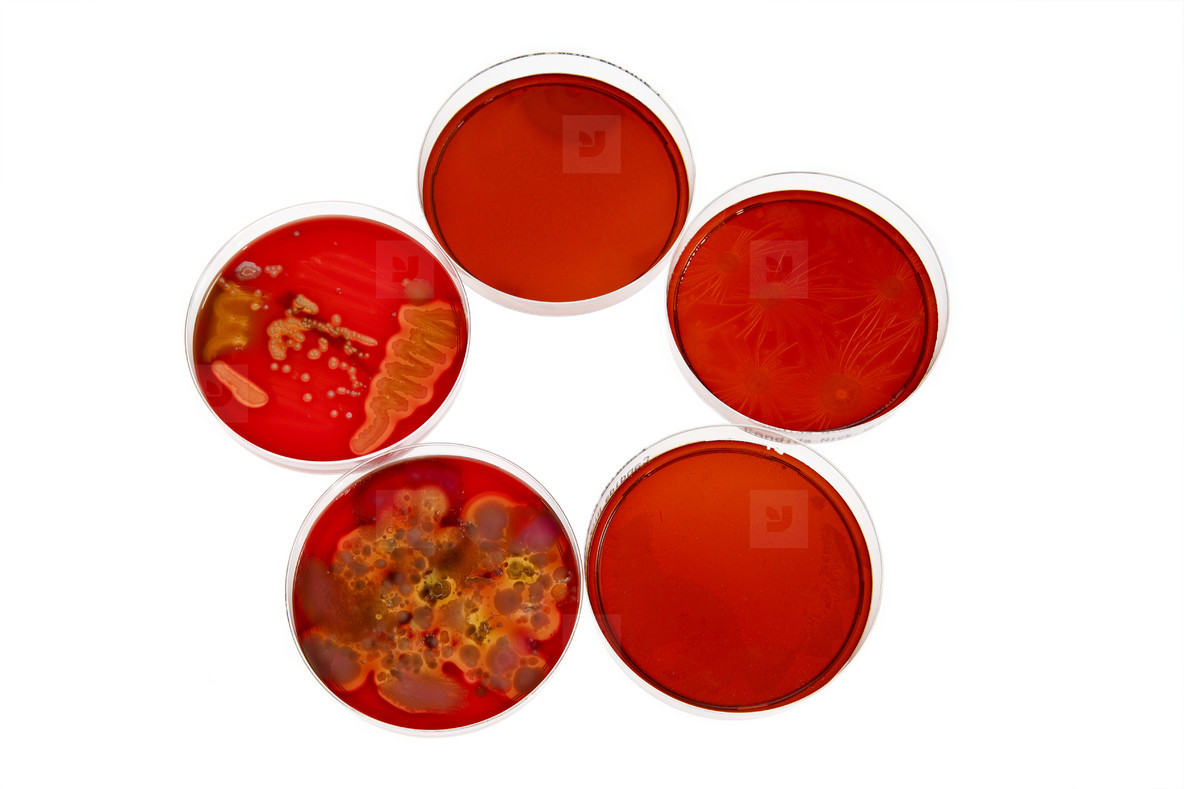
Lab Technicians  31

Register now for instant access to an exclusive collection of Free Fonts, Graphics, and Photos.
Please check your email to verify your account. RESEND
- All Items
- Fonts
- Graphics
- Photos
- Videos
- Extras
Forgot Password?
New Here?
Register now for instant access to an exclusive collection of Free Fonts, Graphics, and Photos.
Register now for instant access to an exclusive collection of Free Fonts, Graphics, and Photos.
Register now for instant access to an exclusive collection of Free Fonts, Graphics, and Photos.
Lab Technicians #31 Photo
Lab Technicians #31 Stock Photo - #98566
A collection of five petri dishes with different bacterial cultures on red agar medium, showcasing various microbial growth patterns and colony formations used in microbiology research.
Additional Information: Petri dishes holding different stages of bacteria cultures. Photo by Antenna.
A collection of five petri dishes with different bacterial cultures on red agar medium, showcasing various microbial growth patterns and colony formations used in microbiology research.
Additional Information: Petri dishes holding different stages of bacteria cultures. Photo by Antenna.
JPEG - 5019 x 3346px
This product is provided in JPEG image format. JPEG images can be opened and edited by all major image and document layout applications.
fStop is a Berlin-based photo agency that launched in 2002 with the goal of providing the design community with an alternative to the cliché-ridden world of stock photography. Up until late 2014 fStop was part of Fontshop International, a company which was founded by designers Erik Spiekermann and Neville Brod...
EXIF Details
Close
Free Fonts & Graphics Await!
There are currently 245,000 Fonts and 749,000 graphics available for download at YouWorkForThem.
The Original Creative Marketplace | Copyright © 2001-2025 YouWorkForThem. All Rights Reserved.
We accept Visa, MasterCard, American Express, Discover, Apple Pay & PayPal.